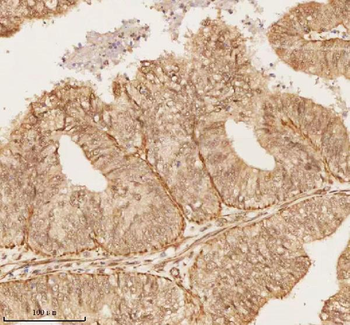
NUP43 Antibody
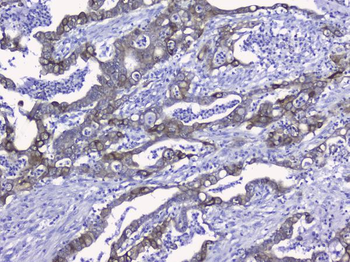
Cytokeratin 19/KRT19 Antibody

You have no items in your shopping cart.
- Osteoprotegerin/TNFRSF11B Antibody [orb570415]
ELISA, FC, IHC, WB
Human, Monkey, Mouse, Rat
Rabbit
Polyclonal
Unconjugated
100 μg - CD11c antibody [orb13554]Featured

ICC, IF, IHC-P, WB
Guinea pig, Human, Mouse, Rat
Rabbit
Polyclonal
Unconjugated
100 μg - CD4 antibody [orb4830]Featured

ELISA, ICC, IF, IHC-P, WB
Human, Mouse, Rat
Rabbit
Polyclonal
Unconjugated
100 μg - NUP43 Antibody [orb1939812]
ELISA, FC, ICC, IF, IHC, WB
Human, Mouse, Rat
Rabbit
Polyclonal
Unconjugated
100 μg - Alpha-Tubulin Antibody [orb344425]
ELISA, IF, IHC, Multiplex Assay, WB
Human
Mouse
Monoclonal
Unconjugated
100 μg - PSMA1 Recombinant Rabbit Monoclonal Antibody [orb608059]Featured

FC, ICC, IF, IHC-Fr, IHC-P, WB
Human, Mouse, Rat
Mouse, Rat
Rabbit
Recombinant
Unconjugated
100 μl, 50 μl - Cytokeratin 19/KRT19 Antibody [orb316578]
FC, ICC, IF, IHC, WB
Human, Mouse, Rat
Rabbit
Polyclonal
Unconjugated
100 μg - EpCAM Rabbit Polyclonal Antibody [orb10183]Featured

FC, IF, IHC-Fr, IHC-P, WB
Human, Mouse, Rat
Rat
Rabbit
Polyclonal
Unconjugated
100 μl, 50 μl, 200 μl - PCNA Rabbit Polyclonal Antibody [orb11250]Featured

FC, IF, IHC-Fr, IHC-P, WB
Human, Mouse, Rat
Bovine
Rabbit
Polyclonal
Unconjugated
100 μl, 200 μl, 50 μl